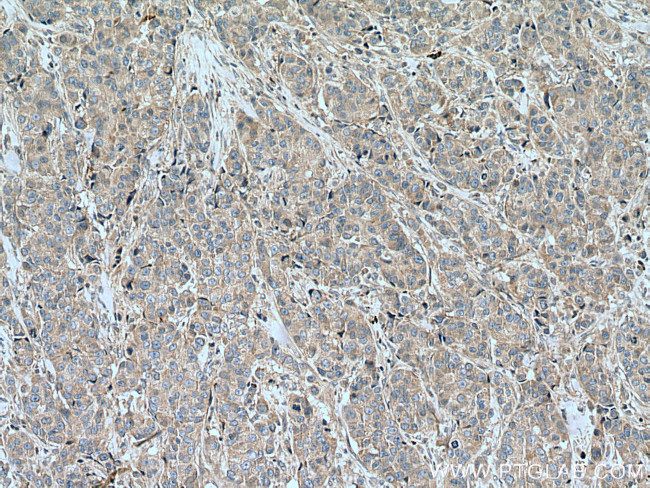
SLC16A5 Antibody in Immunohistochemistry (Paraffin) (IHC (P))

Search
Proteintech
SLC16A5 Polyclonal Antibody
{{$productOrderCtrl.translations['antibody.pdp.commerceCard.promotion.promotions']}}
{{$productOrderCtrl.translations['antibody.pdp.commerceCard.promotion.viewpromo']}}
{{$productOrderCtrl.translations['antibody.pdp.commerceCard.promotion.promocode']}}: {{promo.promoCode}} {{promo.promoTitle}} {{promo.promoDescription}}. {{$productOrderCtrl.translations['antibody.pdp.commerceCard.promotion.learnmore']}}
产品信息
12120-1-AP
种属反应
宿主/亚型
分类
类型
抗原
偶联物
形式
浓度
规格
纯化类型
保存液
内含物
保存条件
运输条件
产品详细信息
Aliquoting is unnecessary for -20°C storage.
靶标信息
MCT5 (SLC16A4, Solute Carrier Family 16 Member 4) is a Protein Coding gene. Gene Ontology (GO) annotations related to this gene include symporter activity and monocarboxylic acid transmembrane transporter activity. Proton-linked monocarboxylate transporter. Catalyzes the rapid transport across the plasma membrane of many monocarboxylates such as lactate, pyruvate, branched-chain oxo acids derived from leucine, valine and isoleucine, and the ketone bodies acetoacetate, beta-hydroxybutyrate and acetate.
仅用于科研。不用于诊断过程。未经明确授权不得转售。
篇参考文献 (0)
生物信息学
蛋白别名: MCT 5; MCT 6; monocarboxylate transporter; Monocarboxylate transporter 5; Monocarboxylate transporter 6; putative monocarboxylate transporter; solute carrier family 16 (monocarboxylate transporter), member 5; solute carrier family 16 (monocarboxylic acid transporters), member 5; Solute carrier family 16 member 5; solute carrier family 16, member 5 (monocarboxylic acid transporter 6); unnamed protein product
基因别名: A130015N09Rik; MCT 5; MCT 6; MCT5; MCT6; SLC16A5
UniProt ID: (Human) O15375, (Mouse) G5E8K6
Entrez Gene ID: (Human) 9121, (Mouse) 217316